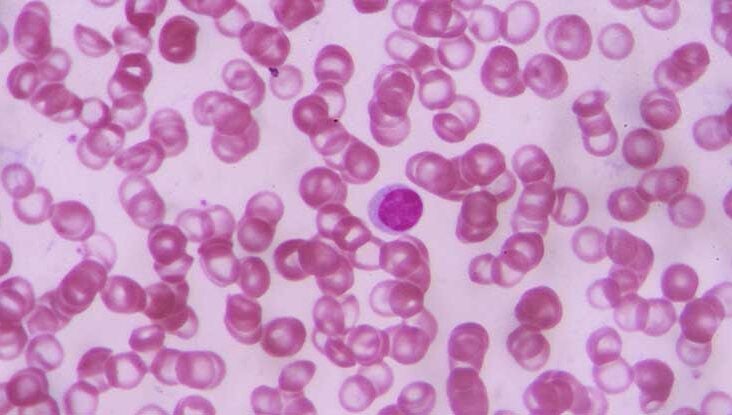

is there a cure for sickle cell anemia
 new sickle cell disease treatment From Pinterest
new sickle cell disease treatment From Pinterest

new medicines in the pipeline to treat sickle cell disease 2020 09 18 bioworld

siklos hydroxyurea for the treatment of children with sickle cell anaemia clinical trials arena

treatment options for sickle cell disease

efficacy and safety of recently approved drugs for sickle cell disease a review of clinical trials experimental hematology

study points to potential treatment for sickle cell disease national institutes of health nih

treatment sickle cell anemia world sickle cell vector image
possible sickle cell disease cure discovered whp

sickle cell anemia the oncofertility consortium

what is sickle cell anaemia facts yourgenome org

improved gene therapy in sickle cell disease technology networks

the pathophysiology of sickle cell disease and sites where drug download scientific diagram
sickle cell anemia miellekartta

challenges of developing and facilitating access to new sickle cell disease therapies case of the deferoxamine patch

current challenges in sickle cell disease

sickle cell anemia physiopedia

ucla stem cell researchers develop promising method to treat sickle cell disease ucla

explainer one day science may cure sickle cell anaemia

sickle cell anemia what you should know personalized hemonc
sickle cell anemia symptoms causes treatments
new sickle cell disease treatment

scientists are developing a game changing sickle cell disease drug bbc science focus magazine

advances in the management of sickle cell disease

gene therapy for sickle cell disease novartis shoots for one time treatment

sickle cell disease pain management

cleveland clinic trial to test gene therapy as treatment of sickle cell disease cleveland clinic newsroom

sickle cell anemia symptoms sickle cell trait treatment britannica

nice recommends first sickle cell disease treatment in 20 years

reaching toward a cure for sickle cell disease the daily

two new drugs help relieve sickle cell disease but who will pay the new york times

exciting advancements made on sickle cell anemia cryo cell

6 signs and symptoms of sickle cell anemia in children

viruses for the good gene therapy for sickle cell disease dna science

potential gene therapy based treatment for sickle cell disease scd download scientific diagram

stem cell transplantation in patients with sickle cell disease intechopen

sickle cell disease overview

ijns free full text sickle cell disease genetics pathophysiology clinical presentation and treatment html

about sickle cell disease

sickle cell disease for kids nemours kidshealth
1








